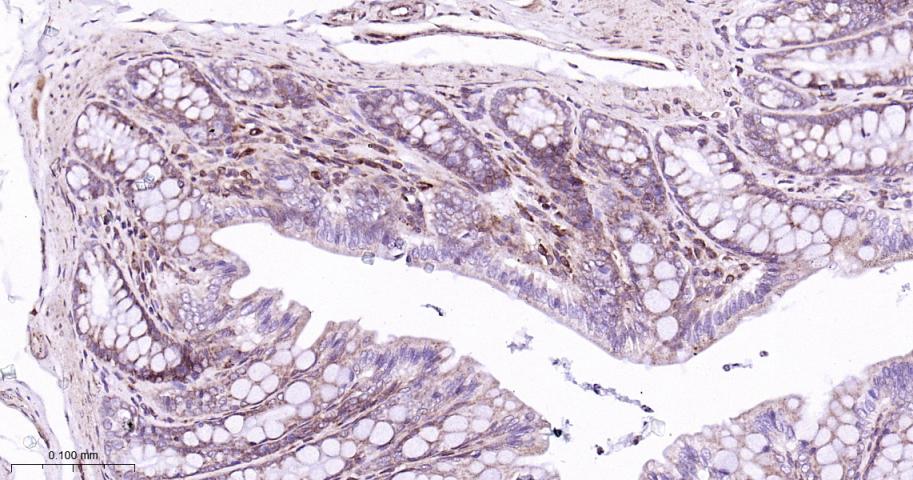
RAS癌基因相关蛋白RAB7重组兔单抗

RAB7A Recombinant Rabbit mAb (一抗) - WB,IHC-P,IHC-F,IF,Flow-Cyt,ICC/IF | Bioss
Rrmab?兔单抗

货号:bsm-60647R
产品详情
相关标记
相关产品
相关文献
常见问题
概述
产品编号
bsm-60647R
产品类型
重组兔单抗
英文名称
RAB7A Recombinant Rabbit mAb
中文名称
RAS癌基因相关蛋白RAB7重组兔单抗
英文别名
CMT2B; PRO2706; RAB7; Rab7a; RAB7A_HUMAN; 3.6.5.2; RAB7A_MOUSE; RAB7A_RAT; Ras-related protein BRL-RAS; Ras-related protein p23;
抗体来源
Rabbit
免疫原
A synthesized peptide derived from human Rab7A: 150-207/207
亚型
IgG
性状
Liquid
纯化方法
affinity purified by Protein A
克隆类型
Recombinant
克隆号
R2B4
理论分子量
23 kDa
检测分子量
23 kDa
浓度
1mg/ml
储存液
0.01M TBS (pH7.4) with 1% BSA, 0.02% Proclin300 and 50% Glycerol.
研究领域
SWISS
Gene ID
保存条件
Shipped at 4℃. Store at -20℃ for one year. Avoid repeated freeze/thaw cycles.
注意事项
This product as supplied is intended for research use only, not for use in human, therapeutic or diagnostic applications.
数据库链接
背景资料
Members of the RAB family of RAS related GTP binding proteins are important regulators of vesicular transport and are located in specific intracellular compartments. RAB7 has been localized to late endosomes and shown to be important in the late endocytic pathway. In addition, it has been shown to have a fundamental role in the cellular vacuolation induced by the cytotoxin VacA of Helicobacter pylori.

产品应用
| 应用 | 已检合格种属 | 预测种属 | 推荐稀释比例 |
|---|---|---|---|
| WB | Human, Mouse, Rat | 1:500-2000 | |
| IHC-P | Human, Mouse, Rat | 1:100-500 | |
| IHC-F | Human, Mouse, Rat | 1:100-500 | |
| IF | Human, Mouse, Rat | 1:100-500 | |
| Flow-Cyt | Human, Mouse, Rat | 1:50-100 | |
| ICC/IF | Human, Mouse, Rat | 1:50-200 |
交叉反应
交叉反应: Human, Mouse, Rat
相关产品
暂无相关产品
靶标
基因名
RAB7A
蛋白名
Ras-related protein Rab-7a
亚基
Interacts with RILP. Interacts with PSMA7. Interacts with RNF115. Interacts with FYCO1
亚细胞定位
Late endosome. Lysosome. Cytoplasmic vesicle, phagosome. Melanosome. Note=Identified by mass spectrometry in melanosome fractions from stage I to stage IV.
组织特异性
Widely expressed; high expression found in skeletal muscle.
疾病
Defects in RAB7A are the cause of Charcot-Marie-Tooth disease type 2B (CMT2B) [MIM:600882]; also known as hereditary motor and sensory neuropathy II (HMSN2). CMT2B is a form of Charcot-Marie-Tooth disease, the most common inherited disorder of the peripheral nervous system. Charcot-Marie-Tooth disease is classified in two main groups on the basis of electrophysiologic properties and histopathology: primary peripheral demyelinating neuropathy or CMT1, and primary peripheral axonal neuropathy or CMT2. Neuropathies of the CMT2 group are characterized by signs of axonal regeneration in the absence of obvious myelin alterations, normal or slightly reduced nerve conduction velocities, and progressive distal muscle weakness and atrophy. CMT2B is clinically characterized by marked distal muscle weakness and a high frequency of foot ulcers, infections and amputations of the toes. CMT2B inheritance is autosomal dominant.
相似性
Belongs to the small GTPase superfamily. Rab family.
功能
Involved in late endocytic transport. Contributes to the maturation of phagosomes (acidification).
同靶标产品
相关文献
提示: 发表研究结果有使用 bsm-60647R 时请让我们知道,以便我们可以引用参考文章。作为回馈,资料提供者将获得我们送上的小礼品。
具体参考文献:bsm-60647R 被引用于1文献中